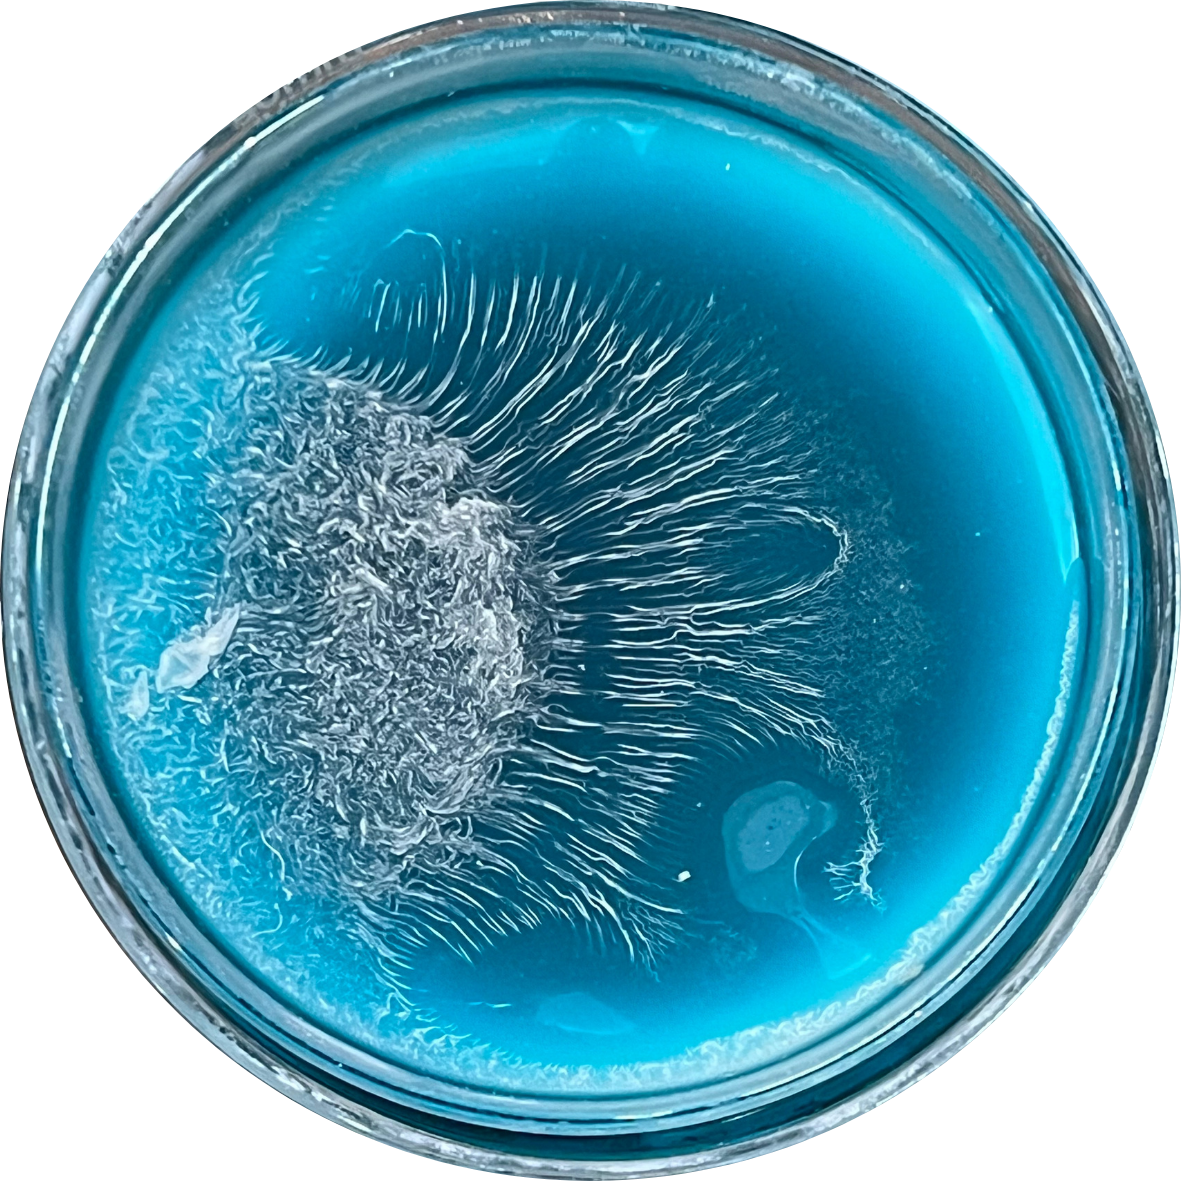

Ablations: Cultures of Loss
or, the Existential Climate Crisis as Taxidermy

Ablations:
Cultures of Loss
Tom Pearson, 2026
Mixed media: Acrylic resin and pigment in borosilicate glass, over aromatic herbs (mountain sage, cedar, and lavender) in copper and tin prayer bowls.
4” Dia. x 2.5” H each
Artist Statement, The Grief En/Counter: Ablations is an intimate study of a disappearing world. By capturing the vastness of a melting glacier within the clinical circle of a Petri dish and framing it inside a prayer bowl, I offer up climate crisis as an environmental, biological, and spiritual monument, with an apology to each sacred direction. Through the unpredictable "wrinkling" of resin—a visceral metaphor for the compression, folding, and eventual disappearance of ice sheets—I map the elegant disintegration of our cryosphere—focusing a global catastrophe into a quiet, tactile moment of personal grief and meditation. By bringing the scale of melting polar caps down to fit the palm of a hand—and invoking a multi sensorial experience through visual, tactile, auditory, and olfactory invitations—I hope to transform an unfathomable global phenomenon into a hauntingly immediate and personal encounter.









